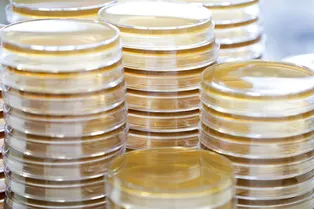

Николай Кудрявцев
Редактор

Как слепые видят сны?

Дробовик против лобового стекла: есть ли у машины шанс?
Как взломать машину с помощью вируса в ДНК?

Взрыв аккумулятора под гидравлическим прессом

Генномодифицированные свиньи: надежда трансплантологии

Первая плазменная ракета готова к испытаниям

Летящие облака на Марсе: таймлэпс от «Кьюриосити»

Пчелы единственные из насекомых понимают абстрактную концепцию

Как заставить тело думать, что вы занимаетесь физкультурой, не вставая с дивана?

Как менялась температура на Земле за последние 116 лет?

36 зданий за 20 секунд: глобальный городской снос

Новый боевой шлем американских пехотинцев: словно из НФ-боевика

Батарейка, заряжающаяся от человеческой слюны

Насколько огромным был самый большой динозавр на Земле?

Самодельный мини-вулкан с настоящей лавой

Найдены главные распространители фейковых новостей

Каково жить с раздвоением личности?

На Земле есть жизнь даже в чистой кислоте

Прорыв в медицине: лечение внутренних органов одним прикосновением
